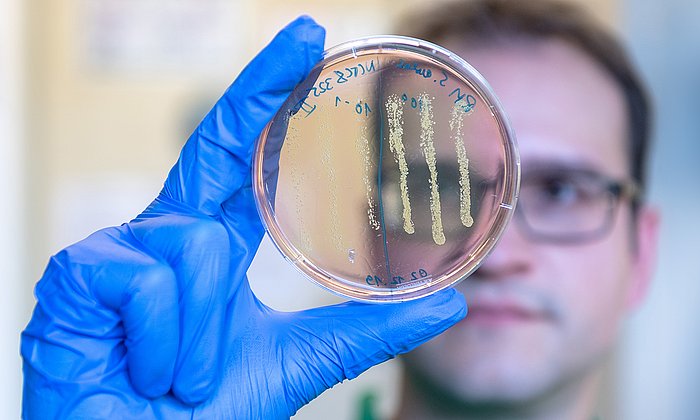
PhD-student Robert Macsics examining an agar plate on which colonies of the Staphylococcus aureus bacteria have grown. The color change of the plate from red to yellow in the area of the bacterial colonies indicates that they are bacteria of the species S. aureus.

Smartbax nominated for Falling Walls award
Start-up dedicated to developing new antibiotics

Rising numbers of bacteria are developing resistance to antibiotics. Studies have shown that hundreds of thousands of people die every year due to infections with antibiotic-resistant pathogens. One group of bacteria alone – methicillin-resistant Staphylococcus aureus (MRSA), which is commonly found in hospitals – causes tens of thousands of deaths each year.
A research team at TUM has discovered an active agent to which multi-resistant MRSA bacteria are unlikely to develop resistance. “While conventional antibiotics target either the cell wall of bacteria or their metabolic system, we aim to permanently impair protein transport and energy balance in the bacteria, which prevents them from multiplying or developing resistances,” explains Stephan Sieber, Professor of Organic Chemistry. Sieber has founded a start-up together with his former doctoral student, Dr. Robert Macsics, to continue developing the new agent.
Bacterial cell wall digests itself
The foundations for this innovation were laid in the laboratories at TUM. “It was pure basic research to begin with,” emphasizes Sieber. “We tested hundreds of different agents in cultures with Staphylococcus aureus and came across a molecule that kills the bacteria off very effectively. We then examined the mode of action of this molecule, which we call PK150.” The results showed that PK150 has a fundamentally different mode of action to conventional antibiotics. Instead of suppressing biochemical processes, PK150 stimulates the excretion of proteins in the cell wall. Key enzymes are discharged from the cells and, in effect, the cell walls begin to digest themselves. At the same time, the molecule blocks the metabolic system, which means the cell cannot store any more energy and dies. Due to this dual mode of action, it is exceptionally unlikely that bacteria will develop mutations with resistances to this agent.
“Once it became clear that this molecule is a promising candidate for the development of a new antibiotic, we both knew we wanted to develop the agent,” recalls Sieber. “It is suitable for combating Staphylococcus aureus and other multidrug-resistant bacteria that are gram-positive, which means they have a single layer cell wall.” TUM applied for a patent for the structure of the optimized molecule for the first time in 2017 while Sieber and Macsics began the search for investors. Even during the coronavirus pandemic, the two researchers secured the support of the Boehringer Ingelheim Venture Fund following a virtual pitch.
Support in a TUM Venture Lab
Soon after, in 2021, the duo founded smartbax – one of the first start-ups accepted into the new TUM Venture Lab ChemSPACE. Each TUM Venture Lab specializes in a significant technological field. Start-up teams benefit from specific technical infrastructure, tailored training programs, expertise in the relevant market and global industry networks. “The opportunity to use the infrastructure and laboratory spaces at the Venture Lab was immensely helpful for us as we took our first steps as an independent company,” says Macsics, who became the start-up’s CEO after completing his doctorate. “There’s also the Venture Lab’s network, which continuously helps us to make new contacts.”
Smartbax now has three permanent employees, with Stephan Sieber assisting as a scientific consultant. In addition to developing the active agent, the company is working on other strategies to combat drug-resistant bacteria. It aims to have its first drug candidates ready for clinical trials within a few years.
25 nominees from around the world
The Falling Walls jury identified the team’s work as one of the most potentially significant breakthroughs of the year. The eponymous charitable foundation hosts the Falling Walls Science Summit on November 9 each year. The event marks the fall of the Berlin Wall and strives to highlight the walls torn down by science to a wide audience. The summit is one of the most important events linking research with wider society and is also a key date in the scientific calendar.
Falling Walls names Science Breakthroughs of the Year in five fields of research and in the Science Start-Up category. Smartbax has been nominated along with 24 other start-ups from Europe, the Americas, Asia and Australia.
-
In addition to smartbax, a second TUM spin-off has been nominated for the Science Breakthrough of the Year in the Science Start-Up category at the Falling Walls summit. Reverion has developed micro power plants that, on the one hand, use biogas more efficiently than conventional plants. On the other hand, they can automatically switch to the production of green hydrogen or methane when there is a surplus of solar or wind energy in the grid. The start-up emerged from the BioCORE research project of a team from the Chair of Energy Systems and the Professorship of Regenerative Energy Systems at the TUM Campus Straubing for Biotechnology and Sustainability. It was supported in the TUM Venture Lab ChemSpace.
- Every year around 70 technology-oriented companies are founded at TUM – at the center of one of Europe’s most innovative deep tech ecosystems. TUM and UnternehmerTUM, Center for Innovation and Business Creation, provide programs tailored to the various phases of building a business – from creating the business model to management training, and from market entry to a possible IPO. The TUM Venture Labs offer an entire research ecosystem for start-up teams working in important scientific fields. Up to 30 teams can use the TUM Incubator to prepare for the launch of their companies. Through its own venture capital fonds , UnternehmerTUM invests in tech companies displaying strong potential. Meanwhile, with MakerSpace, it provides a 1500 square meter high-tech prototype workshop.